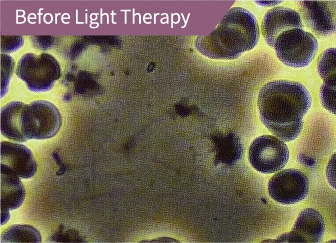
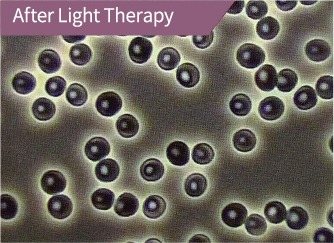

SmartBoard
智慧平衡檢測
訓練設備
電競版 全新上線



SmartMotion

SmartMotion
特色介紹

安卓遊戲支援
邊玩遊戲邊健身,分析每個遊戲所消耗的熱量,徹底落實熱量消耗控制。

熱量分析圖表
不同遊戲類型,從基礎平衡到益智競速,各年齡層皆適合遊玩。

自我訓練
針對需要加強之專案,訂定標靶目標,多樣化分析圖表分析落點。

互動課程
進階專業訓練影音課程,針對個人需求,跟著教練動一動。
輕鬆開啟智能體感運動的大門
Smarrboard是一款兼顧健身,減肥及體感娛樂的劃時代產品。可提供平衡力,肌耐力(包含腿部耐力,上肢耐力,核心肌群耐力)及肌控力、旋轉力等訓練。內建陀螺儀 及重力六軸感測技術,可提供有別於Wii,更棒的體感體驗,運用身體力量與擺動幅度去操控遊戲進行。除可提供專業訓練外,不喜愛運動的朋友也可以藉由遊玩體感遊戲達到減肥健體效果。只要在Smarrboard上遊玩遊戲或跟著互動健身影片一起運動,在遊戲結束時程式都會依據使用者的身高,年齡及體重換算期間消耗的卡路里儲存至雲端,並且將統計資料繪製成圖表方便使用者瞭解自身的運動情形。
特色說明
居家訓練娛樂兼健身
綁定使用者手機,用APP快速掃描登入系統,健康資訊不外流。
居家訓練娛樂兼健身
綁定使用者手機,用APP快速掃描登入系統,健康資訊不外流。
規格訊息
產品名稱 |
SMARTBOARD |
板面 |
板面是由高品質12-14mm高壓楓樹板製作而成,可以承受400KG(瞬間重量) |
阻尼器 |
控制板面旋轉速度 |
安全栓 |
限制平衡板的旋轉(可調整成固定及可旋轉270度) |
彈簧 |
車用等級彈簧 |
身體檢測 |
肌耐力 肌控力 平衡力旋轉力 |
互動課程 |
32項課程,每項課程3分鐘,包含上肢、下肢及核心肌肉 |
互動體感遊戲 |
我們的目的是在創建「運動兼遊戲、遊戲間運動」,讓所有人都能參與及熱愛運動。 |
智慧功能說明
二、 重量分段:12段。
三、 設備可自動偵測並提供設備所有運動參數,包括:運動角度、距離、時間、次數、組數、重量、起始點、終止點等各數據參數。
四、 設備包含獨立Android主機平台操作系統,Android主機平台操作系統功能包含如下:
a. 產生二維碼,供使用者登入個人ID。
b. 使用者可自行設定訓練課程之角度、次數、組數、重量、起始點、終止點等訓練參數。
c. 使用者可透過顯示屏,可即時監看訓練目標參數執行狀況,及即時顯示運動角度變化現狀。
d. 系統自動偵測運動訓練參數起始點及終止點位置,當使用者達到運動訓練起始點及終止點時,系統會自動發出提示音提示使用者。
e. 系統自動偵測使用者運動訓練動作,是否確實達到訓練參數設定之起始點及終止點位置,並完整一個循環皆做到位後,系統才可以計數一次。
f. 使用者完成訓練後,系統會透過區網wifi自動上傳所有運動數據至雲端伺服器。
g. 使用者可從自己的手機APP查看自己所有的訓練紀錄。

HydroLight 高滲透水冷光艙介紹
HydroLight高滲透水冷光艙,是建菱科技所研發及製造之全新全身型『水過濾紅外A』水冷光艙。採用獨家Hydrolight專利技術,保留600-1400奈米波段,把對皮膚有害的紫外光及對眼睛有害的藍光波段濾除,因此在艙內無需戴眼罩,可以看平板玩手機,皮膚還不會變黑! 大部分類似的設備,皆是採用兩三種不同「單波長」的LED燈做組合,效果較為單一;而水冷光艙是「全波長」,對人體吸收光能量的效果更加全面,可有效提升人體核心溫度達38°C~40°C,啟動人體自我修復功能。 一般遠紅外線設備與水冷光艙的最大差異在於,遠紅外線設備是「由外而內」的熱,透過大幅提升環境溫度促使身體排汗,這樣所排的汗為一般「汗線」的汗,目的是為了「降溫」;水冷光艙是「由內而外」的熱,採用冷光低溫運行,艙內溫度控制在溫和的34°C左右,卻能讓身體因為持續吸收wIRA短波能量提升核心溫度,並透過「皮脂腺」大量排汗,排出對身體有害的酸性物質、自由基及重金屬等,達到真正意義上的深層排毒。重點是對身體或皮膚不會有灼熱等不適感。 水冷光艙也包含了「633奈米」紅光波段,可改善血液循環,促進新陳代謝,激發原生的修復功能,將老化的黑色素與角質快速代謝,同時也因刺激成纖細胞,它會生成一型及少量四型膠原蛋白,達到美白嫩膚的效果。因此HydroLight高滲透水冷光艙,是內在排毒、外在修補的絕佳聖品!
HydroLight 高滲透水冷光艙快速入門

高滲透水冷光技術
- - 獨家專利
- -採 600-1400nm全波長光波
- -非LED 單一波長
- -光幅照度大幅提升3-5倍 ,
- -可深入組織 15-25cm

波長
- -遠紅外線 :長 (7000-14000nm)
- -IRA:短 (780-1400nm)
光滲透率
- -遠紅外線:淺,皮下組織0.5cm內
- -IRA:深,皮下組織3-5cm內
- (透過Hydro-Light技術可達15-25cm)
溫度
- -遠紅外線 :透過外在高溫提升表面溫度
- -IRA:自體提升核心溫度38-40度
排汗
- -遠紅外線 :汗腺 (目的是降溫)
- -IRA:皮脂腺 (目的是排毒)
功能
- -遠紅外線 : 促進血液循環、減緩痠痛、增加代謝
- -IRA:除了上述功能,能真正做到細胞內排酸、排毒

皮膚有兩種腺體:「汗腺」,「皮脂腺」
- -汗腺汗液:散熱作用,排出水分、少量自由基、鹽分、尿素、尿酸等
- -皮脂腺汗液:排毒作用,除散熱作用,排出水分、少量自由基、鹽分、尿素、尿酸等外,能帶出體內重金屬、細胞內的酸、大量自由基及部分脂肪

汗液顏色所代表的健康問題
您知道汗液有顏色的嗎? 根據《黃帝內經》五行五臟五色對應表,
每種顏色代表著不一樣的健康問題
黑色汗液 | 鉛汞重金屬累積腎負擔的健康問題
紅色汗液 | 心血管或婦科疾病健康問題,藥物殘留
灰白汗液 | 肺、淋巴系統的健康問題
黃色汗液 | 脾、胃的健康問題
青綠色汗液 | 肝、膽的健康問題
藍色汗液 | 體內積存過多化學物質的健康問題
Hydro-Light技術即是國際wIRA技術的延伸,保留人體最需要的「600nm~1400nm」波段,而一般國際定義的紅外線波段為:
| 光輻射 | 波長 | 光輻射 | 波長 |
|---|---|---|---|
近紅外線 |
780nm~3000nm |
wIRA |
780nm~1400nm |
| 中紅外線 | 3000nm~50000nm | IRB | 1400nm~3000nm |
| 遠紅外線 | 50000nm~1000000nm | IRC | 3000nm~1000000nm |
Complementary & Innovative Cancer Therapy
統合醫學的癌症治療是和現代醫學一起必不可少 !

整合癌症治療的目標是通過免疫調節和細胞凋亡機制控制癌症。
當現代醫學療法與各種經過科學證明的補充療法相結合時,
就可以實現這樣的目標,這些療法最終可以改善患者的生活質量並提高生存率。
近紅外線相關影片與網站資訊連結分享
創新的整合醫學治癌在整合醫學癌症治療上溫熱治療的重要性
1)全身熱療法在癌症治療中的地位和臨床效果
2)近紅外線的原理適用於現代人的癌症 , 代謝性疾病 , 血管疾病和 神經退行性疾病的治療
3)專家對近紅外療法的見解
全身熱療法在癌症治療中的地位和臨床效果
使用與現代醫學上的提高深部溫度的代表性方法是可以根據目標溫度分為三種方法。
醫療用
- 高強度聚焦超聲(HIFU-High-Intensity Focused Ultrasound)-通過聲能將癌細胞內的目標溫度提高到72°C以上,進而讓癌細胞壞死。
- 局部溫熱療法 (Local Hyperthermia)- 通過電磁波將癌細胞的溫度提高到 42-48° C,逐漸破壞癌組織。

醫療輔助用 + 保養用
- 全身溫熱療法 (Wholebody Hyperthermia)- 最近受歡迎的方式是以近紅外線為中心的Hydro-light照射全身,使全身溫度升高到38-40° C。